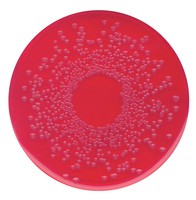

| Tên sản phẩm: | BPLS agar for the isolation of Salmonella Merck |
| Tên gọi khác: | Brilliant-green phenol-red lactose sucrose agar, Brillant-green phenol-red lactose sucrose agar |
| Code: | 1072320500 |
| Hãng – Xuất xứ: | Merck – Đức |
| Ứng dụng: | – Là môi trường nuôi cấy chọn lọc để phân lập Salmonella ngoại trừ S. typhosa và Shigella |
| Tính chất: |
– Màu sắc: màu đỏ – Mật độ khối: 600 kg/m3 – Giá trị pH: 6.8 – 7.0 (52 g/l, H₂O, 37 °C) – Độ tan: 52 g/l |
| Bảo quản: | Bảo quản từ +15°C đến +25°C |
| Quy cách: | Chai nhựa 500g |

Đánh giá
Chưa có đánh giá nào.